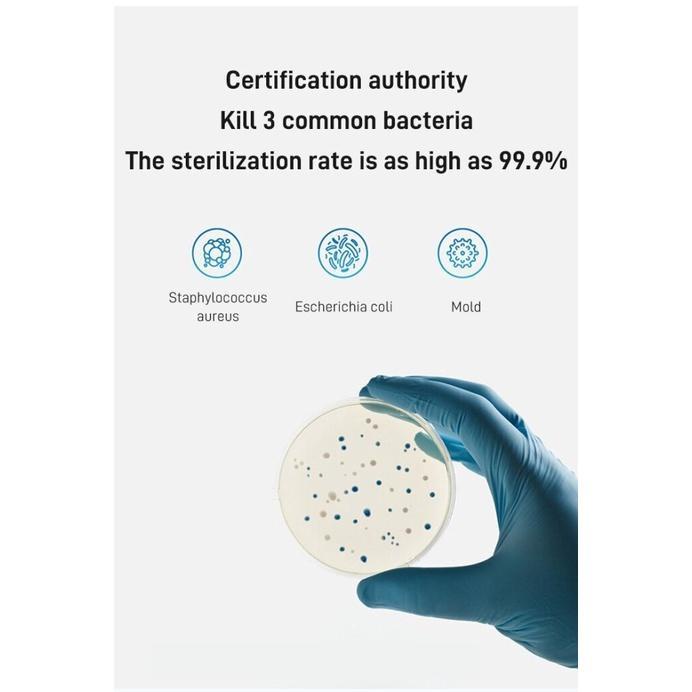

1/8
2 Variations Available
Fully automatic intelligent sweeping robot Smart Sweep Vacuum Cleaner Cordless Wireless Robotic 2 in 1 Vacuum Mop Sweep
Guaranteed to get by 14 Apr
Free shipping
Get a RM5.00 voucher if your order arrives late.
15-Day Free Returns • Cash on Delivery • Electronic Protection Service Program